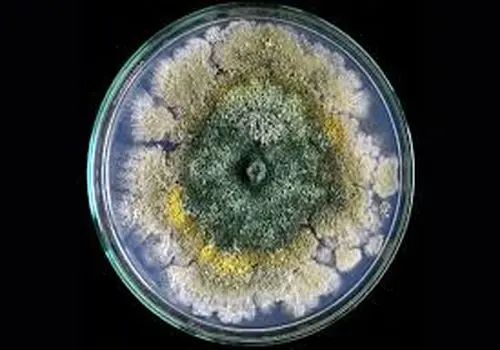

چرا پنیر در یخچال کپک می زند؟

کپک زدن پنیر در یخچال یکی از مشکلات رایج نگهداری مواد غذایی است که با شناخت عوامل موثر و رعایت اصول صحیح نگهداری قابل پیشگیری می باشد.
به گزارش پارسینه ،کپک زدن پنیر یکی از مشکلات رایجی است که ممکن است برای هر کسی پیش بیاید. این پدیده نه تنها به لحاظ بهداشتی نگران کننده است بلکه می تواند به هدر رفتن مواد غذایی منجر شود. در این مقاله، به بررسی علل کپک زدن پنیر در یخچال، عوامل موثر در این پدیده، روش های پیشگیری و راهکارهای مناسب خواهیم پرداخت.
پنیر یکی از محبوب ترین محصولات لبنی است که در انواع مختلفی تولید می شود. از پنیرهای نرم مانند پنیر خامه ای و موتزارلا گرفته تا پنیرهای سفت و قدیمی تر مانند چدار و پارمزان، همگی ممکن است دچار کپک زدن شوند.
عوامل موثر در کپک زدن پنیر
۱. رطوبت
رطوبت یکی از عوامل کلیدی در کپک زدن پنیر است. پنیر در محیط های مرطوب می تواند به سرعت دچار فساد شود. کپک ها با جذب رطوبت و رشد در دماهای مناسب، به راحتی می توانند روی سطح پنیر ایجاد شوند. بنابراین، نگهداری پنیر در ظروف مناسب و خشک می تواند کمک شایانی به جلوگیری از کپک زدن آن کند.
۲. دما
دمای نگهداری پنیر نیز تاثیر بسزایی در کپک زدن آن دارد. پنیر باید در دمای مناسب یخچال (بین ۰ تا ۴ درجه سانتی گراد) نگهداری شود. دماهای بالاتر از این محدوده می تواند به رشد کپک ها و باکتری ها منجر شود. بنابراین، همیشه باید از دمای یخچال خود مطمئن باشید و پنیر را در نقاط سردتر آن قرار دهید.

۳. کیفیت پنیر
کیفیت پنیر نیز در کپک زدن آن موثر است. پنیرهای تهیه شده از شیر پاستوریزه معمولاً کمتر دچار کپک می شوند. به علاوه، برخی پنیرها به صورت طبیعی دارای کپک هستند، مانند پنیرهای آبی. این نوع پنیرها خود کپک هایی دارند که برای انسان خطرناک نیستند اما در صورت نگهداری نادرست، می توانند به کپک های ناخواسته تبدیل شوند.
۴. بسته بندی
بسته بندی پنیر یکی دیگر از عوامل مهم است. پنیرهایی که در بسته بندی های غیرمناسب و بدون عایق مناسب نگهداری می شوند، بیشتر در معرض کپک زدگی قرار دارند. استفاده از کیسه های زباله، نایلون های مخصوص پنیر یا ظروف هوابند می تواند به جلوگیری از ورود رطوبت و کپک کمک کند.
روش های پیشگیری از کپک زدن پنیر
نگهداری در دمای مناسب
پنیر باید در دمای یخچال نگهداری شود. همچنین، می توانید پنیر را در گوشه های یخچال که معمولاً خنک تر هستند، قرار دهید. دقت داشته باشید که از یخچال های قدیمی که ممکن است دماهای غیرطبیعی داشته باشند، استفاده نکنید.
استفاده از ظروف مناسب
استفاده از ظروف شیشه ای یا پلاستیکی با درب مناسب می تواند به جلوگیری از ورود رطوبت و کپک کمک کند. همچنین، برخی از تولیدکنندگان پنیر ظروف خاصی ارائه می دهند که به حفظ تازگی و جلوگیری از کپک زدن کمک می کند.

خشک کردن پنیر
قبل از ذخیره پنیر، حتماً از خشک بودن آن اطمینان حاصل کنید. در صورتی که پنیر مرطوب باشد، احتمال کپک زدن آن افزایش می یابد. می توانید از دستمال تمیز یا کاغذ مخصوص استفاده کنید تا پنیر را خشک کنید.
استفاده از نمک
استفاده از نمک به عنوان یک نگهدارنده طبیعی می تواند به جلوگیری از کپک زدن پنیر کمک کند. برخی افراد برای نگهداری پنیر، کمی نمک روی آن می پاشند تا رطوبت آن کاهش یابد و از ورود کپک ها جلوگیری شود.
برچسب گذاری
برچسب گذاری پنیر با تاریخ تولید و تاریخ انقضا می تواند به شما کمک کند تا به موقع از آن استفاده کنید و از کپک زدن آن جلوگیری نمایید. همچنین می توانید از روش های مختلف نگهداری پنیر برای انواع مختلف آن آگاه باشید.
.svg)

ارسال نظر